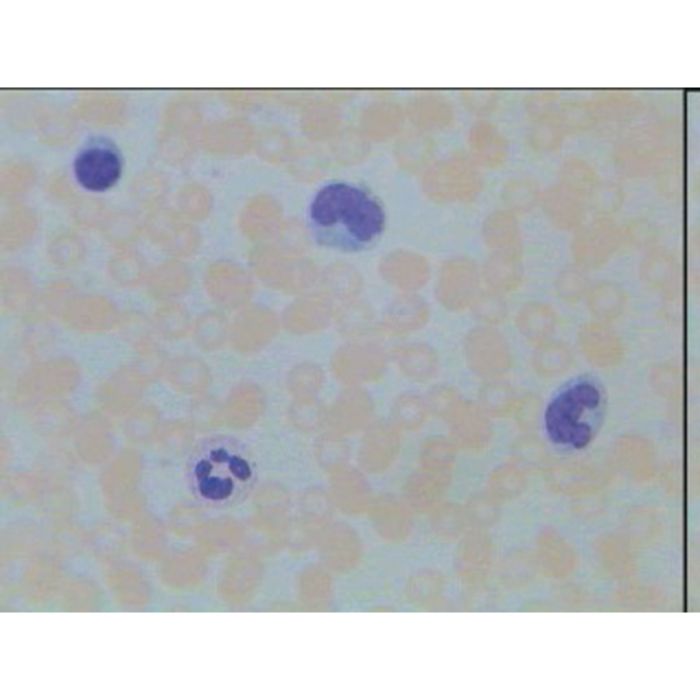

The home of Specialist Crafts
Checkout using your account
Checkout as a new customer
Creating an account has many benefits:
Human blood smear
| Web Price | AED 56.00 |
|---|---|
| Web Code | FELHC1006564 |
| Alternative Codes | FELHC1006564, HC1006564 |
| Pack Size | Each |